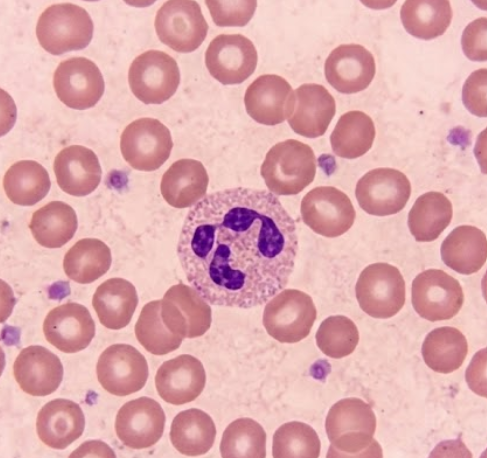
segmented neutrophil
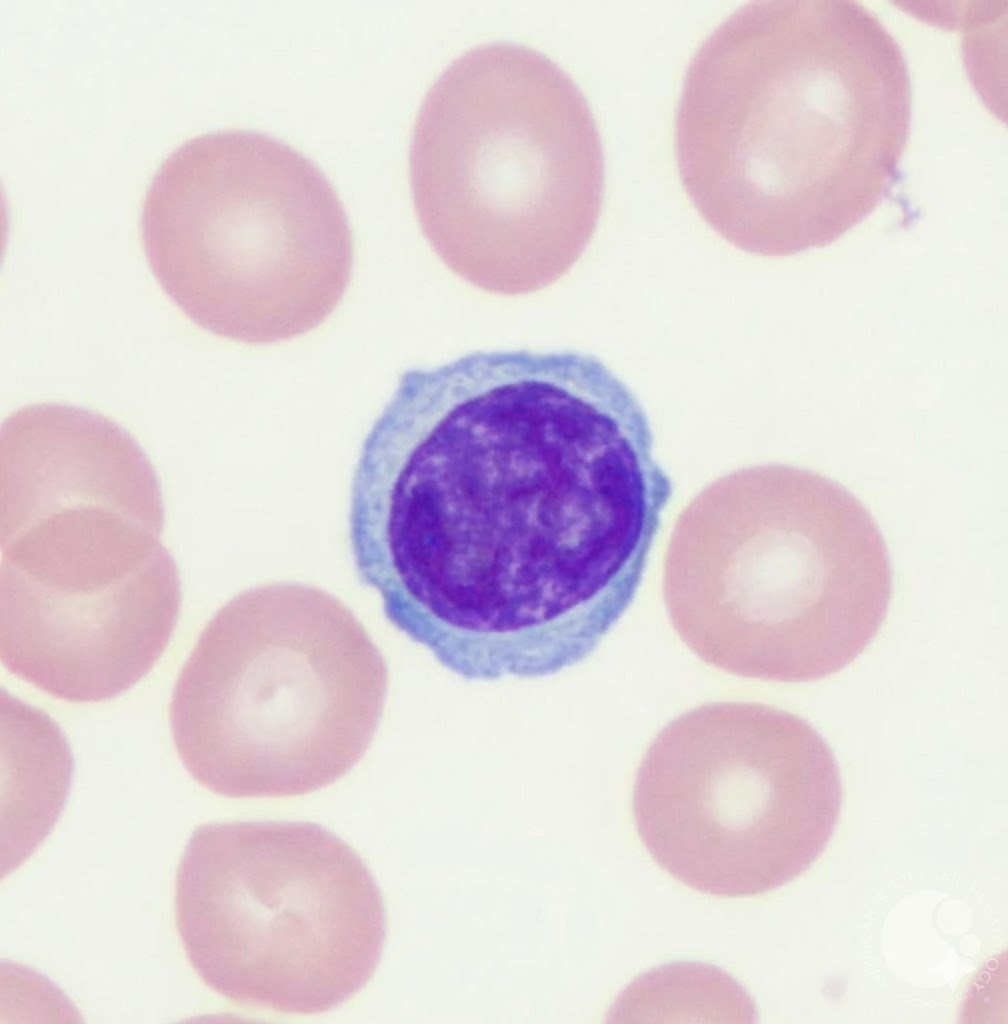
lymphocyte
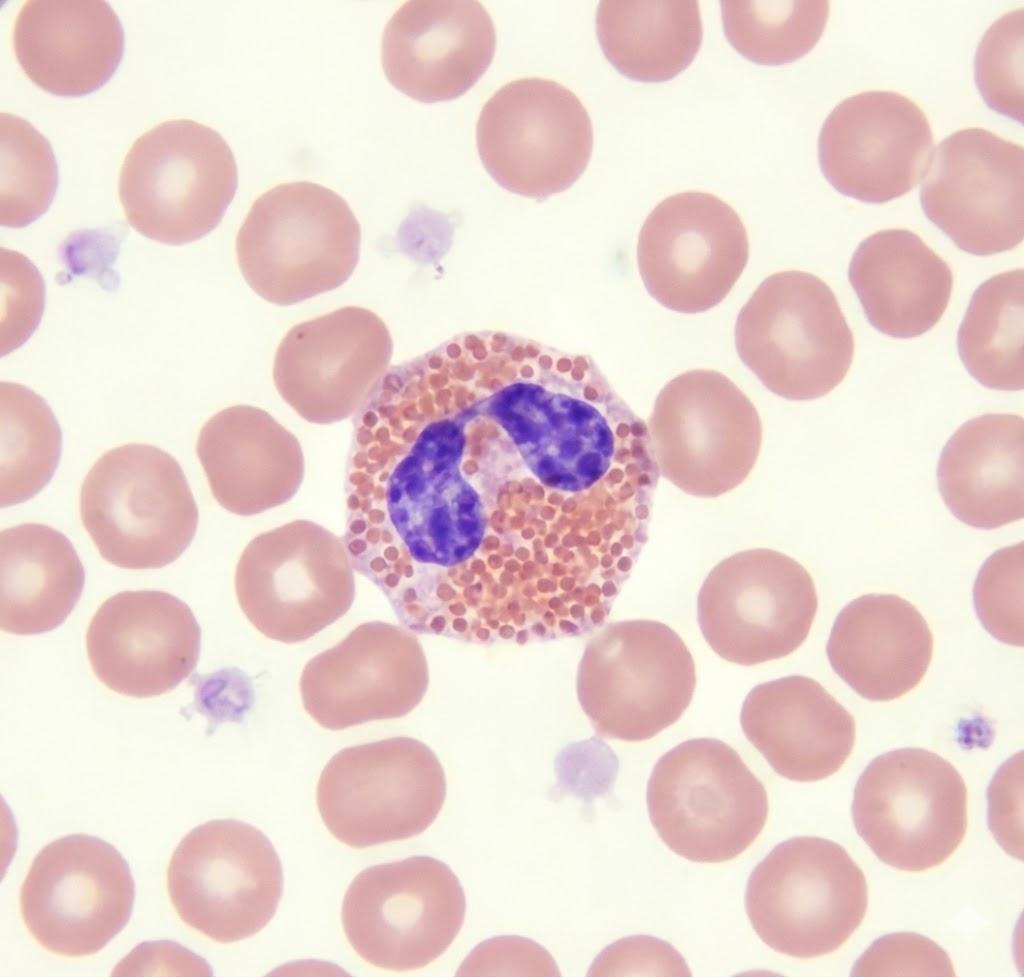
eosinophil
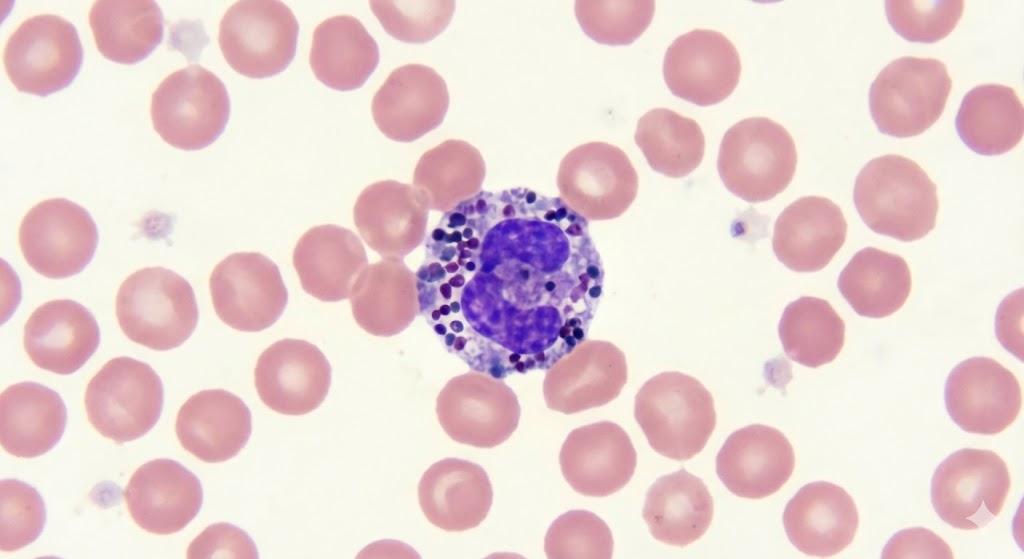
basophil

White Blood Cells
Below is an image of a peripheral blood smear.

This means that a clinical laboratory scientist took a drop of a patient's blood, skillfully smeared it to created a fanned out shape as shown in the image above, and then stained it with a special stain called the Wright-Giemsa stain.
The five different types of white blood cells are:
- Neutrophils
- Lymphocytes
- Monocytes
- Eosinophils
- Basophils
Let's examine each of these cells individually.
Neutrophils
Neutrophils are the most abundant type of white blood cell, making up 40-70% of all white blood cells. They are the first type of white blood cell to arrive at the site of an injury or infection, and their primary function is to destroy bacteria and fungi.
Below is an image depicting the identifying parts of a neutrophil.

Below is what a segmented neutrophil looks like under a microscope.
Also seen in the image are red blood cells. And if you look closely, you'll also see some smudgy purple dots—those are platelets.
Lymphocytes
Lymphocytes are the second most abundant type of white blood cell, and they make up 20-40% of all white blood cells. Lymphocytes attack infected cells and produce antibodies.
Below is an image depicting the identifying parts of a lymphocyte.

Below is what a lymphocyte looks like under a microscope.
Monocytes
Monocytes are the third most abundant white blood cells, making up 2-8% of all white blood cells. Monocytes float around in blood circulation until they encounter an infection or inflammation, which triggers them to migrate into tissues and become macrophages or dendritic cells. Monocytes consume bacteria and fungi, but they also consume dead cells, cellular debris, and foreign matter. These cells are critical for the adaptive immune response.
Below is an image depicting the identifying parts of a monocyte.

And below is what a monocyte looks like under a microscope.

Eosinophils
Eosinophils are the fourth most abundant white blood cells, making up 1-4% of all white blood cells. Eosinophils fight off multicellular parasites that are too large to be engulfed by neutrophils. These cells attached to a parasite and release toxic granules to destroy it from the outside. Eosinophils also play a role in allergic reactions.
Below is an image depicting the identifying parts of an eosinophil.

And below is what an eosinophil looks like under a microscope.
It is worth noting that the above image (just like all the images on this site) is AI-generated. I tried to carefully prompt Gemini to produce realistic images of cells under a microscope. However, I ran into a strange issue where when I tried to politely prompt Gemini with corrections to the images it was generating, it would repeatedly run into an "unexpected error" in the chat. I suspect this is a safety feature that Google built in where if Gemini begins to display frustration, the chat gets shut down. I bring this up here because the image above is a bit off. The granules inside the eosinophil should be smaller, but I was worried that repeatedly correcting Gemini would lead it to become frustrated again, leading to the chat shutting down.
What interesting times we live in!
Basophils
Basophils are the fifth most abundant white blood cells, making up 0-1% of all white blood cells. Basophils are involved in allergic reactions and inflammation. They release histamine and other chemicals from their granules that cause inflammation and swelling. Basophils are often triggered by IgE antibodies, which are produced by the immune system in response to exposure to allergen.
Below is an image depicting the identifying parts of a basophil.

And below is what a basophil looks like under a microscope.
I think that's a good primer on the white blood cells. I may write more about white blood cells in the future.
-Kairos Anamnesis
Comments? Send me an email! kairosanamnesis@gmail.com